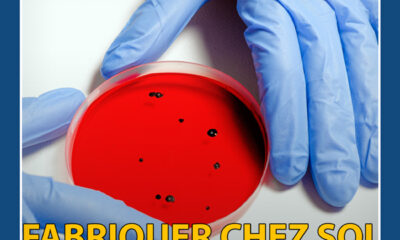

Alors que le virus est toujours très actif et qu'un report des mesures d'assouplissement semblait se profiler, le Premier ministre a réaffirmé la volonté du gouvernement...


Selon plusieurs rumeurs, le MEDEF organiserait régulièrement, et depuis très longtemps déjà, des réunions réservées exclusivement aux riches. Enquête.


Scorpion : Vous ferez un rêve érotique qui se déroule pendant le débat de l’entre-deux tours, avec Marlène Schiappa et Cyril Hanouna. Si vous êtes un...